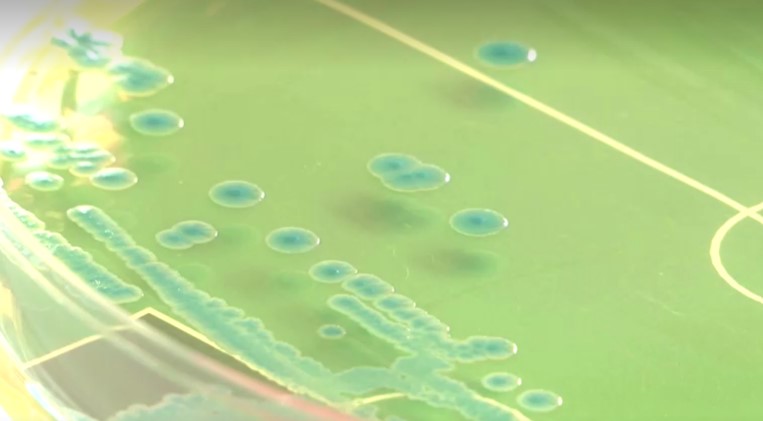

เบอร์ลิน 5 มิ.ย. – นักวิทยาศาสตร์ที่เยอรมนีกำลังใช้เชื้อแบคทีเรียอีโคไลช่วยทำนายผลการแข่งขันฟุตบอลของทีมชาติเยอรมนี ในศึกฟุตบอลยูโร 2024 รอบสุดท้ายที่เยอรมนีจะเป็นเจ้าภาพกลางเดือนนี้
ที่ผ่านมามีการนำสัตว์มาทำนายผลการแข่งขันกีฬารายการต่าง ๆ มาแล้วมากมาย ล่าสุดมีความล้ำหน้าไปอีกขั้น เมื่อนักจุลชีววิทยาที่มหาวิทยาลัยเฟิร์ตวังเงิ่น (Furtwangen University) ในเมืองวิลลิงเงิ่น-ชเวนนิงเงิ่น ของเยอรมนีกำลังใช้เชื้อแบคทีเรียอีโคไลช่วยทำนายผลการแข่งขันของทีมชาติ “อินทรีเหล็ก” เยอรมนีที่จะลงแข่งขันในศึกฟุตบอลชิงแชมป์แห่งชาติยุโรป หรือยูโร 2024 รอบสุดท้ายที่เยอรมนีเป็นเจ้าภาพ และจะเปิดฉากขึ้นในช่วงกลางเดือนนี้

มาร์คุส เอเกิร์ต นักจุลชีววิทยาเจ้าของโครงการนี้เผยว่า ใช้เชื้อเอสเชอริเชีย โคไล เค-12 (Escherichia coli K-12) เป็นเชื้ออีโคไลสายพันธุ์ที่ไม่เป็นอันตราย เพราะเป็นเชื้อแบคทีเรียประจําถิ่นที่พบได้ในลําไส้ของคนและสัตว์เลือดอุ่น ไม่ทําอันตรายหรือก่อโรคร้ายแรง อีกทั้งยังเติบโตเพิ่มจำนวนรวดเร็ว และนักวิจัยคุ้นเคยกับเชื้ออีโคไลตัวนี้เป็นอย่างดี โดยนำเชื้ออีโคไลดังกล่าวมาเพาะบนจานเพาะเชื้อที่ออกแบบมาคล้ายกับสนามฟุตบอล ปล่อยให้เชื้ออีโคไลเติบโตแล้วนำผลที่ได้มาตรวจสอบ
เอเกิร์ตเผยว่า ผลที่ออกมาเป็นที่น่าพอใจของแฟนบอลทีมอินทรีเหล็กที่เตรียมลงเปิดสนามรอบแบ่งกลุ่มนัดแรกกับทีมชาติสกอตแลนด์ เนื่องจากพบว่า มีเชื้ออีโคไลรวมกลุ่มกันอยู่จำนวนมากบริเวณกรอบเขตโทษหน้าประตูฝั่งสกอตแลนด์ หมายความว่าเยอรมนีจะเป็นฝ่ายบุกมากกว่า พาบอลไปป้วนเปี้ยนหน้าปากประตูทีมสกอตแลนด์มากกว่า และมีโอกาสทำประตูได้มากกว่า เชื่อว่าเยอรมนีจะเปิดสนามนัดแรกด้วยชัยชนะ
ต้องมาติดตามลุ้นกันว่า เชื้อแบคทีเรียอีโคไล จะทำนายผลการแข่งขันแม่นเหมือนตาเห็นหรือไม่ ในนัดเปิดสนามฟุตบอลยูโร 2024 รอบสุดท้าย ที่จะเปิดฉากขึ้นที่สนามอัลไลแอนซ์ อารีนา ในนครมิวนิก วันที่ 14 มิถุนายนนี้.-815(814).-สำนักข่าวไทย